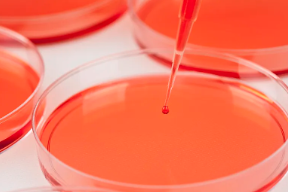
image.png

2007年干細(xì)胞研究有哪些突破?未來(lái)研究方向是什么?
2024-11-01 11:54:34 來(lái)源: 小編 咨詢醫(yī)生
本文將詳細(xì)梳理2007年干細(xì)胞研究領(lǐng)域的重要進(jìn)展,并探討未來(lái)的研究方向。
2007年,干細(xì)胞研究取得了令人矚目的突破,以下是幾個(gè)代表性的進(jìn)展:
1.誘導(dǎo)多功能干細(xì)胞(iPS)技術(shù)的誕生
2007年,日本京都大學(xué)山中伸彌教授領(lǐng)導(dǎo)的研究團(tuán)隊(duì)成功將小鼠皮膚細(xì)胞誘導(dǎo)為具有多能分化潛能的誘導(dǎo)多功能干細(xì)胞(iPS)。這一技術(shù)打破了以往只能從胚胎中獲取多功能干細(xì)胞(ESC)的限制,為干細(xì)胞研究提供了新的途徑。隨后,該技術(shù)迅速被應(yīng)用于人類細(xì)胞,為臨床研究和應(yīng)用帶來(lái)了新的希望。
2.干細(xì)胞治療血液病取得重要進(jìn)展
2007年,美國(guó)波士頓兒童醫(yī)院的研究團(tuán)隊(duì)利用干細(xì)胞移植技術(shù)成功治療了一名患有嚴(yán)重血液病的小女孩。這標(biāo)志著干細(xì)胞治療技術(shù)在血液病領(lǐng)域取得了重要突破,為其他疾病的治療提供了借鑒。
3.肌肉干細(xì)胞研究取得新發(fā)現(xiàn)
2007年,我國(guó)科學(xué)家在肌肉干細(xì)胞研究領(lǐng)域取得重要發(fā)現(xiàn),證實(shí)了肌肉干細(xì)胞在肌肉再生過(guò)程中的關(guān)鍵作用。這一發(fā)現(xiàn)為肌肉損傷和肌肉疾病的治療提供了新的思路。
未來(lái)干細(xì)胞研究的方向如下:
1.安全性研究
隨著干細(xì)胞技術(shù)的不斷發(fā)展,安全性問(wèn)題日益突出。未來(lái)研究將重點(diǎn)關(guān)注如何提高干細(xì)胞治療的安全性,降低副作用,確?;颊叩纳踩?。
2.干細(xì)胞來(lái)源的拓展
目前,干細(xì)胞來(lái)源主要包括胚胎干細(xì)胞、成體干細(xì)胞和誘導(dǎo)多功能干細(xì)胞。未來(lái)研究將致力于發(fā)現(xiàn)更多來(lái)源的干細(xì)胞,以滿足臨床需求。
3.干細(xì)胞治療的個(gè)性化
隨著基因測(cè)序技術(shù)的發(fā)展,未來(lái)干細(xì)胞治療將更加注重個(gè)性化。通過(guò)分析患者的基因信息,為患者量身定制最適合的干細(xì)胞治療方案。
4.干細(xì)胞治療機(jī)制的研究
深入探討干細(xì)胞治療的分子機(jī)制,有助于優(yōu)化治療方案,提高治療效果。未來(lái)研究將重點(diǎn)關(guān)注干細(xì)胞治療的作用機(jī)理,為臨床應(yīng)用提供理論依據(jù)。
5.跨學(xué)科研究
干細(xì)胞研究與其他領(lǐng)域的交叉融合將為干細(xì)胞技術(shù)帶來(lái)更多創(chuàng)新。如與生物信息學(xué)、材料科學(xué)等領(lǐng)域的結(jié)合,有助于開(kāi)發(fā)新型干細(xì)胞治療技術(shù)。
總之,2007年干細(xì)胞研究取得了豐碩的成果,為未來(lái)臨床應(yīng)用奠定了基礎(chǔ)。未來(lái)研究將繼續(xù)關(guān)注干細(xì)胞的安全性、來(lái)源拓展、個(gè)性化治療、治療機(jī)制和跨學(xué)科研究等方面,為人類健康事業(yè)作出更大貢獻(xiàn)。
-
下一頁(yè): 干細(xì)胞有哪些有益作用?如何應(yīng)用于臨床治療?
- 2024-10-16什么是造血干細(xì)胞,造血干細(xì)胞移植需要多少錢(qián)
- 2024-11-11干細(xì)胞供體有什么過(guò)程,有副作用嗎
- 2024-10-14干細(xì)胞干細(xì)胞容器生產(chǎn)商
- 2024-10-24廣州干細(xì)胞能治冠心病嗎,干細(xì)胞移植對(duì)冠心病的好處盤(pán)點(diǎn)
- 2024-10-23干細(xì)胞外泌體能修復(fù)皮膚嗎,外泌體在美容領(lǐng)域的應(yīng)用范圍
- 2024-10-22干細(xì)胞移植中藥效果有哪些?如何選擇?
- 2024-09-14干細(xì)胞注射除皺價(jià)格及其影響因素
- 2024-09-13干細(xì)胞治療糖尿病研究進(jìn)展,干細(xì)胞能治療糖尿病嗎
- 2024-08-09干細(xì)胞的主要功效和副作用
- 2024-09-27貝拉國(guó)際腫瘤醫(yī)院是正規(guī)醫(yī)院?jiǎn)?/a>
- 2024-09-27貝拉國(guó)際醫(yī)療中心是假的嗎
- 2024-09-11國(guó)內(nèi)比較好的干細(xì)胞醫(yī)院排名榜最新
- 2024-10-11干細(xì)胞治療糖尿病一針要花多少錢(qián)?效果能否得到保證?
- 2024-09-15大連國(guó)內(nèi)干細(xì)胞技術(shù),大連干細(xì)胞醫(yī)院哪家好
- 2024-08-02做干細(xì)胞移植要多少錢(qián),做干細(xì)胞移植手術(shù)有風(fēng)險(xiǎn)嗎
- 2024-10-11干細(xì)胞抗衰老效果怎么樣?與普通美容方法有何不同?
- 2024-10-11干細(xì)胞結(jié)合中藥治療腫瘤靠譜嗎?哪些機(jī)構(gòu)值得信賴?
- 2024-08-12打干細(xì)胞對(duì)身體的好壞
